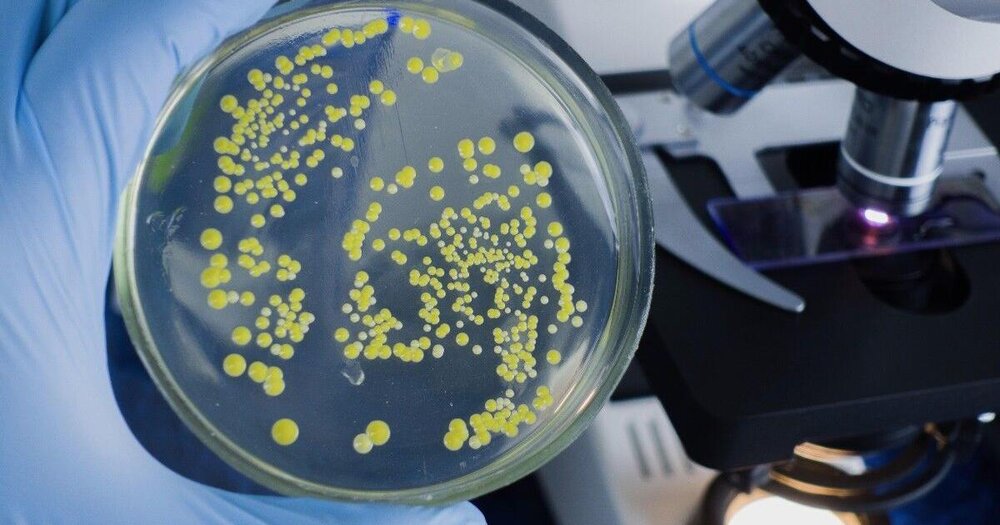
سندرم شوک سمی استرپتوکوک در حال گسترش در ژاپن

پزشکی
-

تصویر روز ناسا: کهکشان غبارآلود از نگاه تلسکوپ فضایی هابل
به گزارش وبگردی، کهکشان NGC 1546 کهکشانی مارپیچی و شبیه به کهکشان خودمان، راهشیری است. این جزیره کهکشانی تقریبا ۵۰…
-

تاثیر استرس بر ذخیره شناختی تا خطر ابتلا به زوال عقل
آفتابنیوز : بر اساس یک تحقیق جدید، استرس میتواند عوامل سبک زندگی را که در راستای بهبود عملکرد شناختی در…
-

سندرم شوک سمی استرپتوکوک در حال گسترش در ژاپن
وبگردی/خراسان رضوی مقامات کشور ژاپن اعلام کردند که عفونت باکتریایی کشنده به نام سندرم شوک سمی استرپتوکوک (STSS) همچنان در…
-
سندرم شوک سمی استرپتوکوک در حال گسترش در ژاپن
وبگردی/خراسان رضوی مقامات کشور ژاپن اعلام کردند که عفونت باکتریایی کشنده به نام سندرم شوک سمی استرپتوکوک (STSS) همچنان در…
-

چینیها تاریخساز شدند؛ شارژ خودروهای برقی در ده دقیقه!
به گزارش خبرگزاری وبگردی، شارژ کردن باتری خودروهای برقی همواره یکی از معایب آنها در مقایسه با خودروهای بنزینی بوده…
-

درمان گرمازدگی در تابستان با روشهای طبیعی و موثر
آفتابنیوز : گرمازدگی وقتی به وجود میآید که شما بیش از توان بدنتان در گرما مانده اید. اگر فکر میکنید…
-

خطری که زنان باردار افسرده را تهدید میکند
وبگردی/خراسان رضوی افسردگی بارداری و پس از زایمان خطر ابتلا به بیماریهای قلبی را افزایش میدهد. هلث گزارش کرد، نتایج…
-

آسمان فردا شب را از دست ندهید؛ ماه دیدنیتر از هر زمان دیگری!
به گزارش خبرگزاری وبگردی، براساس گزارش وبگردی، رصدگران اقیانوسیه در روز ۲۰ ژوئن شاهد عبور ماه تقریبا کامل از مقابل…
-

چگونه دچار سرطان نشویم؟
آفتابنیوز : حسین یحیی زاده مؤسس اولین مرکز درمانی جامع سرطان در نشست خبری افتتاح اولین مرکز درمان سرطان با…
-

درباره بیماری اوتیسم در کودکان
درمان های غیر دارویی برنامه های آموزش ویژه و پایدار یا آموزش اصلاحی و رفتار درمانی در اوایل زندگی می…
-

مدیر بیمارستان قائم رشت برکنار و برخی از مدیران عزل میشوند
وبگردی/گیلان سرپرست معاونت امور مجلس ریاست جمهوری و نماینده ویژه دکتر مخبر با اشاره به قصور برخی از افراد در…
-

گزارش تصویری| شاهکار معمار ژاپنی در شهر جدید چین
به گزارش خبرگزاری وبگردی، هنگامی که با این چشمانداز مواجه میشوید، پارچه وسیع و بیحدوحصری را میبینید که فکر کردن…
-

۵ راهکار ساده برای جوان ماندن مغز
آفتابنیوز : «شما برای شام بیرون میروید. در حین غذا خوردن یک دست روی شانه خود احساس میکنید. صدایی آشنا…
-

چند الگوی غذایی سالم برای افزایش طول عمر
بر اساس یک مطالعه جدید، تنها با داشتن تنوع غذایی و گزینههای بیشتر از بین چهار الگوی غذایی «سالم» میتوانید…
-

یکی از کشورهای پهناور زمین در حال نصف شدن است!/ عکس
تینا مزدکی: هند پس از استرالیا، برزیل و ایالاتمتحده هفتمین کشور پهناور جهان است. این کشور تقریباً ۳.۲۸۷ میلیون کیلومترمربع…
-

موذیترین سرطان چیست؟
آفتابنیوز : سرطان کلیه یکی از ۱۰ سرطان شایع است و اغلب، مردان بالای ۵۰ سال را گرفتار خود میکند.…
-

آیا «تغییر رنگ» نشانه فساد گوشت یا مرغ است؟
هنگام خرید، نگهداری و پخت گوشت و مرغ، رنگ آن اهمیت دارد؛ اغلب یک رنگ جذاب و روشن برای خرید…
-

شیء عجیبی که هنگام خاک برداری پروژه فرودگاهی پیدا شد/ عکس
به گزارش خبرگزاری وبگردی، سازه 1800 متر مربعی عصر برنز در بالای تپه پاپورا در شمال غربی شهر کاستلی، در…
-

نگاهی به علت زانودرد و شیوه درمان آن
آفتاب نیوز : زانو درد شکایت رایجی در میان بسیاری از بزرگسالان است که اغلب با ساییدگی عمومی ناشی از…
-

مرگ 6 حاجی در اثر گرمازدگی
هشدار مقامات سعودی درباره افزایش دمای هوا در طول حج درحالی جدی تر شده که از مرگ 6 حاجی بر…